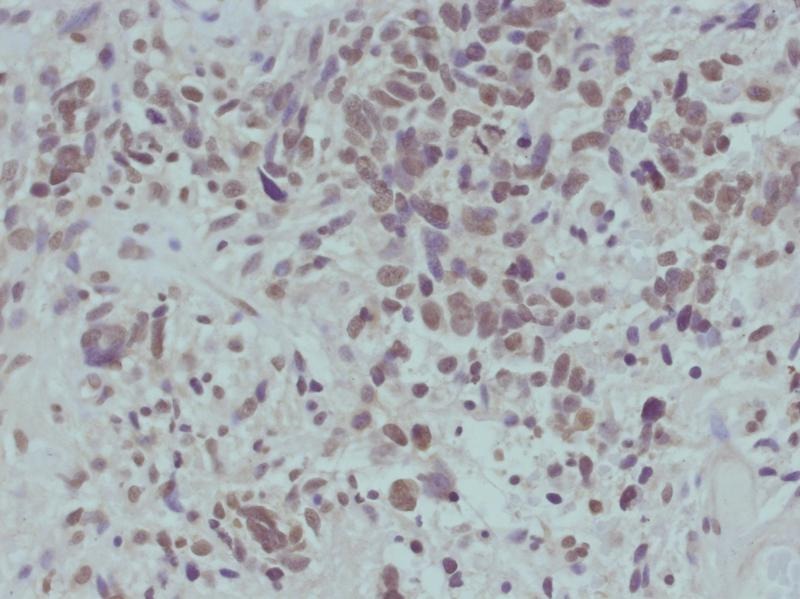

购物车
 您的购物车当前为空
您的购物车当前为空
Anti-Phospho-CTNNB1 (Ser715) Polyclonal Antibody 是一种 Rabbit 抗体,靶向 Phospho-CTNNB1 (Ser715)。Anti-Phospho-CTNNB1 (Ser715) Polyclonal Antibody 可用于 IHC,WB。
别名 p-CTNNB1 (Ser715), p-CTNNB1 (S715), CTNNB1 (p-Ser715), CTNNB1 (p-S715)
Anti-Phospho-CTNNB1 (Ser715) Polyclonal Antibody 是一种 Rabbit 抗体,靶向 Phospho-CTNNB1 (Ser715)。Anti-Phospho-CTNNB1 (Ser715) Polyclonal Antibody 可用于 IHC,WB。
| 规格 | 价格 | 库存 | 数量 |
|---|---|---|---|
| 50 μL | ¥ 1,495 | 5日内发货 | |
| 100 μL | ¥ 2,235 | 5日内发货 |
TargetMol的所有产品仅用作科学研究或药证申报,不能被用于人体,我们不向个人提供产品和服务。请您遵守承诺用途,不得违反法律法规规定用于任何其他用途。
| 产品描述 | Anti-Phospho-CTNNB1 (Ser715) Polyclonal Antibody is a Rabbit antibody targeting Phospho-CTNNB1 (Ser715). Anti-Phospho-CTNNB1 (Ser715) Polyclonal Antibody can be used in IHC,WB. |
| 别名 | p-CTNNB1 (Ser715), p-CTNNB1 (S715), CTNNB1 (p-Ser715), CTNNB1 (p-S715) |
| Ig Type | IgG |
| 反应种属 | Human,Mouse,Rat |
| 验证活性 | 1. Immunohistochemical analysis of paraffin-embedded human primary glioblastoma multiforme (GBM) specimens using beta-catenin (Phospho-Ser715) Antibody TMAC-00428.
2. Western blot analysis of extract from U87 cells transfected with either PKCd siRNA targeting or control siRNA were treated with Wnt3a (100 ng ml 1) for 8 h. WB was performed with nuclearlysates of the cells with the beta-catenin (Phospho-Ser715) Antibody TMAC-00428. |
| 应用 | IHCWB |
| 推荐剂量 | WB: 1:500-1000; IHC: 1:50-100 |
| 抗体种类 | Polyclonal |
| 宿主来源 | Rabbit |
| 构建方式 | Polyclonal Antibody |
| 纯化方式 | Antibodies were produced by immunizing rabbits with synthetic phosphopeptide and KLH conjugates. Antibodies were purified by affinity-chromatography using epitope-specific phosphopeptide. Non-phospho specific antibodies were removed by chromatogramphy using non-phosphopeptide. |
| 性状 | Liquid |
| 缓冲液 | Supplied at 1.0mg/mL in phosphate buffered saline (without Mg2+ and Ca2+), pH 7.4, 150mM NaCl, 0.02% sodium azide and 50% glycerol. |
| 研究背景 | Key downstream component of the canonical Wnt signaling pathway. In the absence of Wnt, forms a complex with AXIN1, AXIN2, APC, CSNK1A1 and GSK3B that promotes phosphorylation on N-terminal Ser and Thr residues and ubiquitination of CTNNB1 via BTRC and its subsequent degradation by the proteasome. In the presence of Wnt ligand, CTNNB1 is not ubiquitinated and accumulates in the nucleus, where it acts as a coactivator for transcription factors of the TCF/LEF family, leading to activate Wnt responsive genes. Involved in the regulation of cell adhesion. Acts as a negative regulator of centrosome cohesion. Involved in the CDK2/PTPN6/CTNNB1/CEACAM1 pathway of insulin internalization. Blocks anoikis of malignant kidney and intestinal epithelial cells and promotes their anchorage-independent growth by down-regulating DAPK2. Disrupts PML function and PML-NB formation by inhibiting RANBP2-mediated sumoylation of PML |
| 偶联 | Unconjugated |
| 其他可选修饰符 | Phospho |
| 免疫原 | Peptide sequence around phosphorylation site of serine 715 (D-P-S(p)-Y-R) derived from Human beta-catenin |
| 抗原种属 | Human |
| Uniprot ID |
| 分子量 | Actual: 92 kDa. |
| 储存方式 | Store at -20°C or -80°C for 12 months. Avoid repeated freeze-thaw cycles. |
| 运输方式 | Shipping with blue ice. |